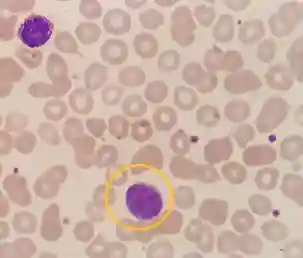

作者|翟文燕王志芳王丽芳张景逍
单位|河北省沧州中西医结合医院
前言
骨髓增生异常/骨髓增殖性肿瘤(MDS/MPN)是一组克隆性造血组织肿瘤性疾患,在就诊时既有一些临床、实验室或形态学表现符合MDS,又有另一些表现符合慢性骨髓增殖性疾病,其临床和血液学特点是骨髓髓系有核细胞增多,其中一系或多系是有效增殖,导致外周血中该系细胞增多,而另一系或多系是无效增殖,导致外周血中该系细胞减少,同时,髓系各系细胞可有发育异常的形态学表现或功能异常[1]。
原发性骨髓纤维化(PMF)属BCR-ABL1(-)骨髓增殖性肿瘤(MPN),其主要特征是骨髓纤维组织增生、髓外造血、贫血、肝脾肿大、体质性症状、进展为白血病和生存缩短。下面与大家分享一例血涂片检查为线索,临床初诊为骨髓增殖性肿瘤(MPN),倾向于原发性骨髓纤维化(PMF)。而后受到骨髓巨核细胞病态造血、易见淋巴样小巨核细胞影响,考虑为MDS/MPN,骨髓活检考虑为PMF,最后会诊结论诊断为PMF的小病例。
案例经过

一、病例简要
患者,男,71岁。两年前体检时发现脾大,未予特殊重视,后逐渐增大,伴食欲差。2021.10.8以“双下肢水肿”就诊于我院放化疗四科。
二、诊断过程
1、血常规结果示:WBC稍升高,NEUT升高,IG明显升高,PLT稍升高。见下图。

2、外周血形态示:原始细胞1%,早幼粒细胞1%,中幼粒细胞11%,晚幼粒细胞5%,易见泪滴红细胞。见下图。
泪滴红细胞

原始细胞
3、临床初步印象
患者巨脾,已入盆腔。WBC、PLT均增高,考虑MPN。由于WBC、PLT均轻度增高,外周血易见幼稚粒细胞、泪滴红细胞,倾向PMF。进行骨髓穿刺。
4、骨髓涂片结果示:结合外周血涂片,考虑MF,不除外MDS,请结合临床及其它相关检查综合分析。

成熟小巨核细胞

淋巴样小巨核

淋巴样小巨核

淋巴样小巨核

5、分子病理结果示:1.本样本检测到CALR基因突变(插入5bp);2.MPLW515基因未检测到突变;3.JAK2基因(Sanger测序,外显子1213)未检测到突变;4.JAK2基因V617突变定量检测(Q-PCR),实时荧光定量PCR阴性(-)。




6、临床思考
临床根据外周血形态、骨髓报告形态描述易见淋巴样小巨核细胞及基因检测结果综合考虑为MDS/MPN。
7、骨髓活检报告示:考虑原发性骨髓纤维化-纤维化期(MF2级),请结合JAK2、CALR及MPL检查助诊。
8、最终诊断
临床最终经北京协和老师会诊诊断为原发性骨髓纤维化(PMF)。
案例分析
这是一例老年男性患者,巨脾,血常规示:WBC稍升高,NEUT升高,IG明显升高,PLT稍升高。血涂片中可见原始细胞,易见幼稚粒细胞、泪滴红细胞。临床初步判断为MPN。骨髓穿刺涂片易见成熟体积小的产板巨、淋巴样小巨核细胞。
分子病理定量检测结论:1.本样本检测到CALR基因突变(插入5bp);2.MPLW515基因未检测到突变;3.JAK2基因(Sanger测序,外显子1213)未检测到突变;4.JAK2基因V617突变定量检测(Q-PCR),实时荧光定量PCR阴性(-)。临床进一步诊断为MDS/MPN。而后骨髓活检考虑原发性骨髓纤维化-纤维化期(MF2级)。经北京协和老师会诊最终诊断为原发性骨髓纤维化(PMF)。
案例总结
明显纤维化期原发性骨髓纤维化的主要诊断标准:
1.有巨核细胞增生和异形巨核细胞,常伴有网状纤维或胶原纤维(MF-2或MF-3),骨髓增生程度年龄调整后呈增高,粒系细胞增殖而红系细胞常减少
2.不能满足真性红细胞增多症、慢性髓系白血病(BCR-ABL融合基因阴性)、骨髓增生异常综合征(无粒系和红系病态造血)或其它髓系肿瘤的WHO诊断标准
3.有JAK2、CALR或MPL基因突变,或无这些突变但有其他克隆性标志,或无继发性骨髓纤维化证据[3]。
骨髓增生异常综合征(MDS)是一组起源于造血干细胞的异质性髓系克隆性疾病,其特点是髓系细胞发育异常,表现为无效造血、难治性血细胞减少,高风险向急性髓系白血病(AML)转化[4]。
MDS主要表现为粒,红和巨核三系病态造血,而巨核系病态主要表现为明显增多的微小巨核细胞,尤其是淋巴样小巨核细胞[5]。因此骨髓中淋巴样小巨核细胞大量出现,临床医生往往就会联想到MDS。
骨髓中淋巴样小巨核细胞的大量出现对于MDS有一定的诊断价值,当骨髓出现巨核细胞病态造血及大量淋巴样小巨核细胞时,我们可以考虑到MDS的可能,但是一定要结合粒、红两系病态造血情况以及原始细胞比例等综合考虑,因为淋巴样小巨核细胞可以见于多种疾病,例如本案例PMF。
据有关文章报道异常巨核细胞与骨髓纤维组织增生和某些骨髓细胞成份改变(如肥大细胞增加)有关[5],且原发性骨髓纤维化诊断标准明确说明有巨核细胞和异形巨核细胞。因此,当骨髓中易见淋巴样小巨核细胞时,一定要结合临床表现、血常规结果、血细胞形态、分子病理检测及骨髓活检综合分析,给患者一个最准确的诊断结论,以免造成误诊误治。
参考文献
[1]王钰,陆焱,顾中华.7例骨髓增生异常/骨髓增殖性肿瘤的临床分析[J].检验医学,2014,10:1074-1075.
[2]肖志坚.我如何治疗原发性骨髓纤维化[J]中国血液学杂志,2019,40(3):179-181.
[3]中华医学会血液学分会白血病淋巴瘤学组.原发性骨髓纤维化诊断与治疗中国指南(2019年版)[J]中华血液学杂志,2019,40(1):1-7.
[4]中华医学会血液学分会.骨髓增生异常综合征中国诊断与治疗指南(2019年版)[J]中华血液学杂志,2019,40(2):89-97.
[5]李晓,浦权,刘慧芝.骨髓增生异常综合征巨核细胞增殖与凋亡的初步研究[J]中国实验血液学杂志,2002,10(1):40-43.